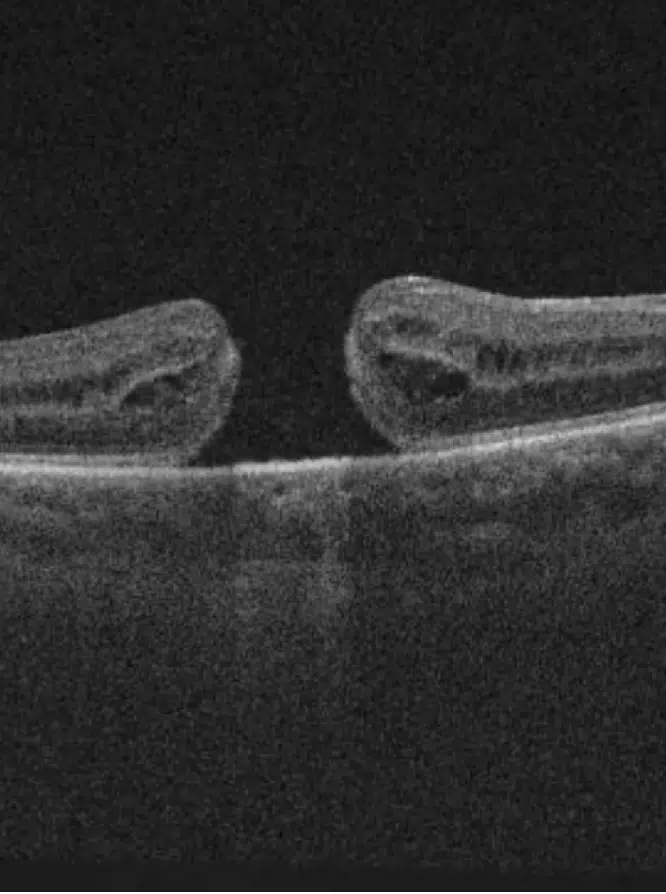

Une intervention chirurgicale rétinienne est parfois indispensable lorsque la vision est menacée par certaines pathologies. Un décollement de la rétine, par exemple, nécessite une action rapide afin d’éviter une perte de vision permanente. L’opération permet alors de fixer la rétine et de restaurer sa fonction.
Chez les patients atteints de rétinopathie diabétique, les vaisseaux sanguins peuvent devenir fragiles et entraîner des hémorragies rétiniennes. Une intervention peut être nécessaire pour prévenir la dégradation de la vision. De plus, certaines anomalies comme la membrane épirétinienne ou le trou maculaire peuvent être corrigées chirurgicalement afin de restaurer la vision.